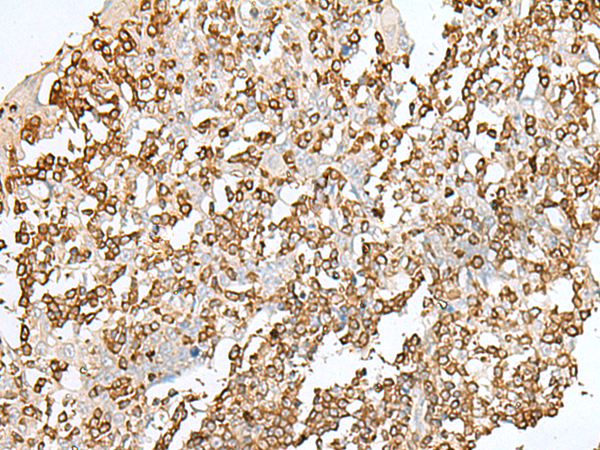
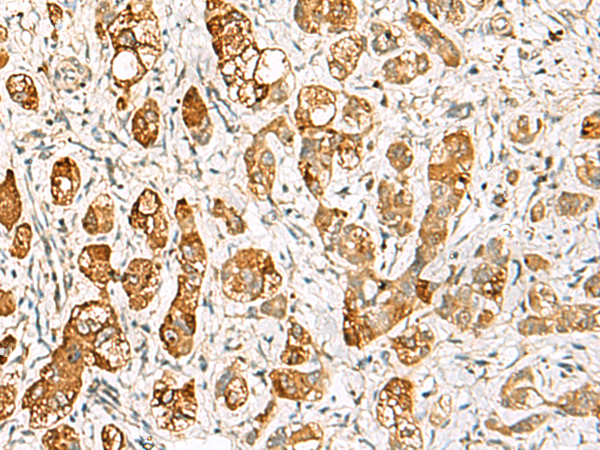

-
分类: 科研抗体货号: P09896别名: LARP; SEP1; DIFF6; SEPT1; PNUTL3应用: IHC反应种属: Human, Mouse, Rat
-
分类: 科研抗体货号: P09875别名: HC8; PSC3应用: WB,IHC反应种属: Human, Mouse, Rat
-
分类: 科研抗体货号: P09911别名: C22orf7; HS323M22B应用: IHC反应种属: Human, Mouse, Rat
-
分类: 科研抗体货号: P09895别名: FKSG21; GKAP42应用: IHC反应种属: Human, Mouse, Rat
-
分类: 科研抗体货号: P09874别名: ORC4L; ORC4P应用: WB,IHC反应种属: Human, Mouse, Rat
-
分类: 科研抗体货号: P09873别名: TASSC; HSPC299; NIPSNAP4应用: WB反应种属: Human, Mouse
-
分类: 科研抗体货号: P09910别名: KBL应用: WB反应种属: Human, Mouse
-
分类: 科研抗体货号: P09893别名: NIM3; RIM3; RIM 3应用: IHC反应种属: Human, Mouse, Rat
-
分类: 科研抗体货号: P09909别名: PAF53; PRAF1应用: IHC反应种属: Human
-
分类: 科研抗体货号: P09892别名: MTf; MFI2; MTF1; CD228; MAP97应用: WB反应种属: Human

鄂公网安备42018502007531号
鄂公网安备42018502007531号

